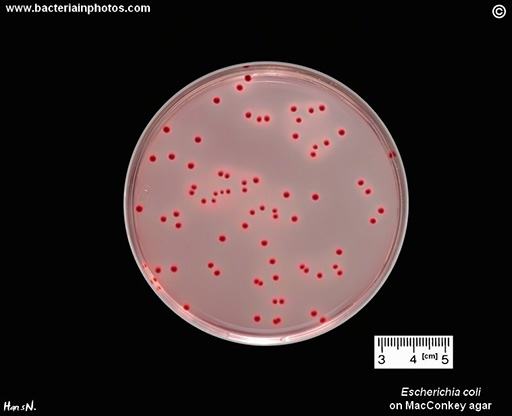
Described image

9.2 AMR indicators
For example, when monitoring trends in humans using untreated sewage, the focus may be on detecting resistant pathogens that are of low prevalence in humans but of high public health relevance. In contrast, when evaluating the effectiveness of an intervention, indicators must be measurable at all times – even if the immediate public health relevance is of less importance. Of course, the indicator of choice is also dependent on the laboratory capacity present in the region, or whether qPCR or sequencing facilities are available or not.
Some studies on AMR in the environment measure genes using qPCR and metagenomics (such as WGS) rather than using culture techniques and quantifying live bacteria. Compared to human and animal surveillance, environmental research more often addresses specific ARGs or metagenomic analyses; however, if the surveillance activity is to support human or animal health, or if the aim is to integrate analyses from different surveillances, choosing an indicator that is meaningful for the human or animal health sectors often means considering culturing and counting bacteria as well.
A common indicator
E. coli is a common indicator of (animal or human) faecal contamination in water and soil (Anjum et al., 2021), and can also harbour ARGs.
The presence of resistant E. coli can be used as a proxy and indicates the presence of (faecal) resistant organisms from human or animal sources. It is also a good candidate for measuring the same microbe across the human, animal and environment sectors, as it is already an established AMR indicator in human and animal health. Because of this, methods for its isolation are often familiar and many protocols exist (Figure 11). On the other hand, focusing on just a single bacterium has the disadvantage that ARGs present in other species are overlooked. This means that analyses of E. coli are not representative of the whole bacterial community.
Activity 8: Selecting indicators
In this activity you will extend the table that you started in Activity 7. An updated version of the table appears in this template [Tip: hold Ctrl and click a link to open it in a new tab. (Hide tip)] with an additional two columns.
Once you have copied in the information from the table in Activity 7, begin this activity by adding any possible AMR indicators that you can think of to the fourth column. Once you have done this, decide if you think these studies on AMR in the environment are suitable for regular surveillance or are research studies, and indicate your answer in the final column.
Discussion
Table 2 shows some possible objectives and indicators. However, your answers will depend on the compartments you have selected and the context that you are working in. Whether or not an indicator is useful for regular surveillance depends to a large extent on cost and the local laboratory testing capacity.
| Compartment | Study area | Objective(s) | AMR indicator(s) | Suitable for regular surveillance? |
|---|---|---|---|---|
| Raw sewage/untreated wastewater | Pathogen of low prevalence with public health concern | Determining trends (in humans) | CPE, ESBL, VRE, fluoroquinolone resistant salmonella (indicators WHO bacterial pathogen list) | Yes |
| Raw sewage/untreated wastewater | Concerns about new forms of resistance | Identifying emerging forms | Resistance genes | Yes |
| Untreated and treated wastewater | Questions about wastewater treatment interventions | Determining the efficacy of intervention | E. coli, ESBL, ARGs | Possible, but more suited to research study |
| Agricultural soil | Concerns about dissemination of AMR by fertilising with manure | Determining trends in AMR | Resistance genes | Yes |
| Drinking water | Questions about treatment options | Determining the efficacy of intervention | Faecal indicators (E. coli) | Yes – depending on the average drinking water quality, it might be more suited to research study |
| Drinking water | Concerns about public health | Producing data for risk assessment | E. coli, ESBL | Yes |
| River water | Attribution of urban and agricultural sources to river concentrations; role of residues for selection of AMR | Determining trends in AMR | AMR indicators or residues | Yes |
| Irrigation water (and irrigated crops) | Questions about irrigations with wastewater | Producing data for risk assessment/determining the efficacy of intervention | E. coli, ESBL-producing E. coli | Possibly, but more suited to research study |
| Air | Concerns about occupational exposure of farmers | Producing data for risk assessment | MRSA, ARGs | More suited to research study |
9.1 Metrics of environmental AMR surveillance

